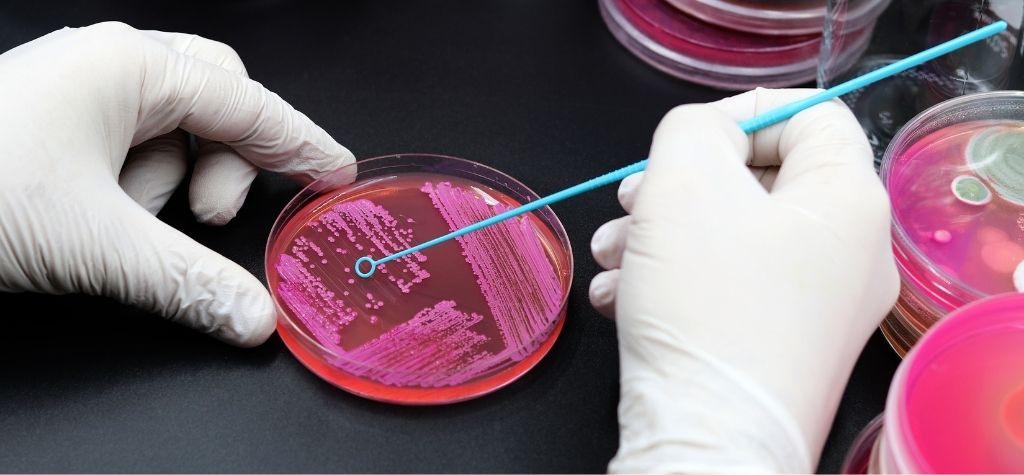
Eye Microbiome Secrets

Why Tiny Bugs Matter
Imagine discovering that your ability to see clearly depends on millions of tiny organisms living on the surface of your eye. These microbes live quietly on the conjunctiva, cornea, tear film and eyelids, and most of them help keep our eyes comfortable and disease‑free. Yet when the balance of these microbes goes wrong, inflammation and vision problems can follow. Recent research has revealed that the eye microbiome—the community of bacteria, viruses and fungi on the ocular surface—plays a vital role in maintaining eye health and may also contribute to diseases like dry eye and even allergies. This article will take you through the eye’s microbiome: what it is, why it matters, how it can become unbalanced, and what you can do to keep your eyes healthy.
Understanding the Human Microbiome
Our bodies host vast collections of microbes—bacteria, viruses, fungi and other tiny organisms. Scientists call these communities the microbiome. Each site on our bodies has its own set of microbes that flourish under specific conditions. For instance, the gut, skin and mouth all have unique microbial communities. The ocular surface is no exception; it harbors bacteria, viruses and fungi that interact with our immune system to preserve eye health. Researchers define the microbiota as the microbial species present in most individuals at a particular site. The ocular surface microbiome (OSM) refers to these organisms living on the conjunctiva, cornea, tear film and eyelid margins.
Where Do Eye Microbes Live?
The eye is not a uniform surface. Different regions host distinct microbial communities:
Conjunctiva
The conjunctiva is a thin membrane covering the white part of the eye and the inside of the eyelids. Studies using high‑throughput sequencing have found that the conjunctiva contains a rich microbiome. In healthy adults, Corynebacterium, Pseudomonas, Staphylococcus, Acinetobacter, Streptococcus and related genera make up about 75 % of the microbial community. Large studies identified over 25 phyla and hundreds of genera; Proteobacteria, Actinobacteria and Firmicutes were the most abundant phyla. Corynebacterium and Pseudomonas were often the most common genera, while Streptococcus and Staphylococcus were less abundant.
Cornea
The cornea is a clear, transparent dome that helps focus light. It has a lower microbial biomass than the conjunctiva because of tear flow and blinking, which constantly wash away microbes. Proteobacteria often dominate the corneal microbiome, and there is less fluctuation in phyla compared with the conjunctival microbiome. Because the cornea is immune‑privileged and lacks blood vessels, it is particularly vulnerable to infection and relies on its microbiome and immune mechanisms for protection.
Eyelid Margin and Meibum
The eyelid margins, including the Meibomian glands, secrete oily meibum that forms the outer layer of the tear film. The eyelids harbor their own microbial communities resembling skin microbes; Staphylococcus epidermidis and Corynebacterium were frequently isolated in studies of meibum. Contact between meibum and the eye means these microbes also influence tear film composition.
Tear Film
The tear film is a complex mixture of water, mucins and lipids that lubricate and protect the eye. Its microbiome likely arises from the conjunctiva, eyelids and Meibomian glands. In healthy individuals, Firmicutes, Actinobacteria and Proteobacteria are the major phyla in tears, with Lactobacillus, Bacillus and Corynebacterium among the most abundant genera. However, tear film microbiota may change in disease; for example, dry eye patients exhibit more Coriobacteriaceae and Bacteroidetes and less Pseudomonas.
Viruses and Fungi
The ocular surface also supports a virome (virus community) and mycobiome (fungal community). Nonpathogenic viruses—particularly bacteriophages—help regulate bacterial populations and contribute to homeostasis. Three virus populations found on the ocular surface are the Multiple Sclerosis‑associated retrovirus, Human Endogenous Retrovirus K and Torque Teno Virus. Among fungi, next‑generation sequencing has detected genera such as Aspergillus, Malassezia, Rhodotorula, Fusarium and Candida. Studies suggest that fungal communities do not vary with age or gender, but an imbalance (dysbiosis) can promote conditions like fungal keratitis.
How the Eye Microbiome Protects Our Sight

First Line of Defense
Our eyes are exposed to the environment every second we are awake. The ocular surface must allow light to pass while preventing microbes from invading deeper tissues. Epithelial cells of the cornea and conjunctiva form a physical barrier and express pattern recognition receptors (PRRs) that recognize microbial molecules called pathogen‑associated molecular patterns (PAMPs). When PRRs detect pathogenic microbes, they trigger signaling cascades that produce pro‑inflammatory cytokines and other molecules to recruit immune cells. Remarkably, these epithelial cells tolerate commensal (beneficial) bacteria but mount an immune response against harmful microbes.
Tear Film and Antimicrobial Molecules
Tears contain mucins, secretory IgA, lysozyme, lactoferrin and antimicrobial peptides such as defensins. These molecules trap microbes, neutralize toxins and inhibit bacterial growth. Tear components also help maintain a slightly acidic pH and provide nutrients that favor beneficial species. Conjunctival goblet cells produce mucin (Muc5AC), defensins and immunosuppressive cytokines like TGF‑β that dampen inflammation and help maintain tolerance to commensal microbes.
Immune Cells
The conjunctiva houses various immune cells—gamma delta T cells, mucosal‑associated invariant T (MAIT) cells, natural killer (NK) cells, B1 cells and regulatory T cells—collectively forming the conjunctival‑associated lymphoid tissue (CALT). Gamma delta T cells release IL‑22 to strengthen the epithelial barrier, while MAIT and NK cells respond to bacterial and fungal antigens. Regulatory T cells and TGF‑β enforce immune tolerance to prevent excessive inflammation. Together, these immune components interact with the microbiome to preserve ocular homeostasis.
Factors That Shape the Eye Microbiome
The composition of the eye microbiome is not fixed. Multiple factors influence which microbes thrive on the ocular surface:
- Age and Sex: Studies found no age‑related changes in fungal diversity and no major gender differences in fungal communities. However, some bacterial genera may vary with age or sex.
- Geography and Environment: Different climates, pollution levels and lifestyles affect the ocular microbiome. Individuals from The Gambia, China and the United States displayed differences in the abundance of certain genera.
- Contact Lens Use: Wearing lenses changes the ocular environment and may introduce microbes from the lens surface or storage solution. In a randomized study, contact lenses stored in hydrogen peroxide solution harbored only 12 unique genera compared with 71 genera in multipurpose solution; lenses cleaned with multipurpose solution had more Corynebacterium, Haemophilus and Streptococcus. Proper lens hygiene, including using peroxide‑based solutions and replacing lens cases, may help reduce harmful bacteria.
- Eyelid Hygiene: Cleaning eyelids with wipes can lower bacterial load. A study applying eyelid wipes twice daily for five days found significantly lower bacterial levels on treated eyelids. Good eyelid hygiene is especially important for people with blepharitis or Meibomian gland problems.
- Antibiotics and Topical Medications: Medications can disrupt the microbiome by killing commensal bacteria or altering pH. Chronic antibiotic use on the eye should be balanced with its potential to induce dysbiosis.
- Diet and Gut Health: Emerging research links the gut microbiome to ocular health. Diets high in sugar and saturated fat can promote gut dysbiosis that may influence ocular inflammation. Conversely, diets rich in fiber support beneficial gut microbes that produce short‑chain fatty acids (SCFAs) which have anti‑inflammatory properties.
When the Microbiome Goes Wrong: Dysbiosis and Disease

Dry Eye Disease
Dry eye disease (DE) causes irritation, burning and blurred vision. It occurs when tear production or tear quality is inadequate. Research suggests that changes in the ocular microbiome contribute to DE. In individuals with DE, microbial diversity is reduced and certain genera—such as Acinetobacter and Corynebacterium—increase. Under gut dysbiosis, microbial antigens can leak into circulation, triggering systemic inflammation and altering the balance of T helper 17 (Th17) and regulatory T (Treg) cells. This imbalance leads to inflammation in the lacrimal gland, reduced tear secretion and damage to the ocular surface. Dry eye patients often have increased levels of pro‑inflammatory cytokines such as IL‑1, IL‑6, IL‑17, TNF‑α and IFN‑γ.
Gut dysbiosis may also induce autoantibody production. Microbial antigens that mimic eye proteins can activate autoreactive B cells, leading to the production of autoantibodies that attack lacrimal glands and cause Sjögren’s syndrome–related dry eye. These findings highlight the importance of both local and systemic microbiome balance.
Meibomian Gland Dysfunction (MGD)
The Meibomian glands secrete oils that stabilize the tear film. When these glands malfunction, tears evaporate too quickly and dry eye develops. Dysbiosis of the eyelid margin may promote bacterial biofilms, which are organized communities encased in a protective matrix. Biofilms attach to glycosaminoglycans on the tear film and form along the eyelid margin. They secrete enzymes that trigger inflammation and obstruct the Meibomian glands, leading to MGD. Patients with moderate or severe MGD often have altered microbial compositions; some studies found higher levels of Cutibacterium acnes, Staphylococcus and Corynebacterium compared with healthy controls.
Allergic Conjunctivitis
Allergic conjunctivitis occurs when the conjunctiva reacts to allergens like pollen or pet dander. While the role of the eye microbiome is still being uncovered, studies show that individuals with allergic eye disease often have lower microbial diversity and changes in the abundance of certain genera. In vernal keratoconjunctivitis, Staphylococcus aureus was isolated in 70 % of patients. For patients with allergic rhinoconjunctivitis, Pseudomonas dominated, while Corynebacterium was significantly lower than in healthy subjects. Sudden disruptions to the ocular microbiome may promote inflammatory responses and chronic allergic conditions.
Infectious Keratitis
The cornea’s low microbial biomass and immune privilege make it susceptible to infection. Contact lens wear is a major risk factor for microbial keratitis. Lenses can introduce Acanthamoeba, Pseudomonas and fungal pathogens. Poor lens hygiene allows pathogenic bacteria to proliferate in lens solutions and on lens surfaces. Using hydrogen peroxide–based cleaning solutions and replacing lens cases reduces contamination.
Glaucoma, Uveitis and Other Diseases
Emerging studies link ocular microbiome changes to other eye conditions such as glaucoma, uveitis and age‑related macular degeneration (AMD). For example, glaucoma patients using topical medications may exhibit a different ocular microbiome compared to those not using drops. The mechanisms are still under investigation, but inflammation and immune modulation likely play roles.
The Gut–Eye Axis: A Two‑Way Street
The gut microbiome influences distant organs through metabolites, immune modulation and neural pathways. Researchers have discovered that gut dysbiosis can contribute to ocular diseases. When the gut barrier becomes “leaky,” bacterial components like lipopolysaccharide (LPS) enter the bloodstream, activate immune cells and trigger systemic inflammation. These activated immune cells can migrate to the eye, releasing cytokines that damage the lacrimal glands and ocular surface.
Reduced production of short‑chain fatty acids (SCFAs), which are anti‑inflammatory metabolites produced by beneficial gut bacteria, can disrupt the balance of Treg and Th17 cells and reduce mucin production. Such changes decrease tear secretion and tear film stability. Diets high in fiber promote SCFA production, while high‑fat or high‑sugar diets increase the growth of harmful bacteria and worsen inflammation.
Modulating the Eye Microbiome for Better Vision

Given the importance of microbial balance, researchers and clinicians are exploring ways to modulate the eye microbiome:
1. Probiotics and Prebiotics
Probiotics are live beneficial bacteria; prebiotics are fibers that feed them. Several studies suggest that oral or topical probiotics may help manage dry eye. In a clinical trial, probiotic mixtures containing Bifidobacterium lactis and Bifidobacterium bifidum improved tear film secretion and increased tear breakup time. Another study found that probiotics with Saccharomyces boulardii and Enterococcus faecium reduced dry eye symptoms and increased tear production. These results are promising but more randomized controlled trials are needed.
2. Dietary Interventions
Because gut health influences the eye, eating a diet rich in fiber, fruits and vegetables may support both gut and ocular microbiomes. Omega‑3 fatty acids from fish and flaxseeds have anti‑inflammatory effects and may help relieve dry eye symptoms. Limiting refined sugar and saturated fat can reduce gut dysbiosis and systemic inflammation.
3. Hygiene and Lifestyle
- Contact Lens Care: Use hydrogen peroxide–based solutions, replace lens cases regularly and avoid sleeping in lenses.
- Eyelid Cleaning: Gently clean eyelids with specially formulated wipes to reduce bacterial load and prevent biofilm formation.
- Avoid Unnecessary Antibiotics: Use antibiotics only when prescribed and follow instructions to prevent microbial imbalances.
- Quit Smoking and Limit Alcohol: These habits can negatively affect both gut and ocular microbiomes.
4. Future Therapies
Researchers are investigating immune modulation and microbiome transplantation as future treatments. Modulating immune pathways like NOD2, which influences bacterial autophagy and immune responses, could help maintain microbial balance. Another emerging idea is ocular microbiome transplants, similar to fecal microbiota transplants used for gut disorders. However, this approach remains theoretical and requires thorough safety testing.
Actionable Tips to Protect Your Eye Microbiome
- Practice Good Hygiene: Wash your hands before touching your eyes, and avoid rubbing your eyes excessively.
- Clean Contact Lenses Properly: Use peroxide‑based solutions, replace lenses as directed and maintain sterile lens cases.
- Maintain Healthy Diet: Eat plenty of fruits, vegetables, whole grains and fermented foods to support a healthy gut microbiome.
- Stay Hydrated: Adequate water intake supports tear production and mucin secretion.
- Get Regular Eye Exams: Early diagnosis and management of eye diseases can prevent complications.
- Consider Probiotics: Discuss probiotic supplements with your healthcare provider if you suffer from dry eye or autoimmune disorders.
Conclusion: Nurturing the Invisible Guardians of Sight
The eye microbiome is an intricate ecosystem that quietly supports our ability to see the world. Beneficial bacteria, viruses and fungi protect against pathogens, modulate immunity and maintain tear film stability. Yet modern lifestyles—contact lens use, poor diet, antibiotic overuse—can upset this delicate balance. Dysbiosis has been linked to dry eye disease, Meibomian gland dysfunction, allergies and other eye disorders. Understanding the factors that shape the eye microbiome empowers us to take proactive steps: practicing good hygiene, caring for our contact lenses, nurturing our gut health and considering probiotics when appropriate.
Research into the ocular microbiome is still young, but it holds exciting possibilities. Scientists are exploring probiotics, immune modulation and even microbiome transplants as future therapies. By appreciating the invisible communities on our eyes and supporting them, we can help safeguard our vision for years to come.
